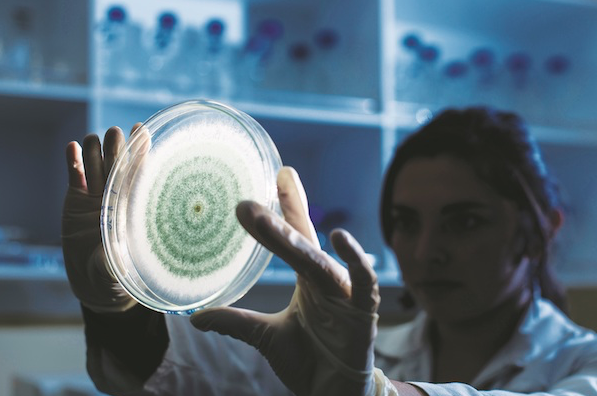

Eventos
- Cooperación internacional en bioproductos en RumaniaEntre el 12 y el 16 de mayo de 2025, la Dra. Cecilia Bustos Ávila, profesora titular de la Universidad del Bío-Bío, participó en una estancia académica Erasmus+ en la Transilvania University of Brașov (Rumania). Durante… Lee más: Cooperación internacional en bioproductos en Rumania
- 6th International Conference on Bio-Based Building Materials (ICBBM 2025).Este congreso es el evento más importante a nivel mundial en materiales de construcción bio-basados. El Dr. Erik Alpizar Reyes presentó los avances del proyecto de investigación sobre encapsulación de… Lee más: 6th International Conference on Bio-Based Building Materials (ICBBM 2025).
- Workshop en Colaboración con UBC – 2025Encuentro técnico-científico centrado en nuevos bioproductos y transferencia tecnológica.
Noticias
- Publicaciones ISI– G. Rodriguez., Bustos ,C., Alain Cloutier. 2025. Impact of bio-based phase change materials on the thermal inertia of panels made from medium-density fiberboard (MDF) residues. Construction and Building Materials, Volume 494, 10 October… Lee más: Publicaciones ISI
- Grupo VB&B se consolida en la Universidad del Bío-BíoEl grupo fue reconocido como Grupo Consolidado de Investigación UBB 2023, fortaleciendo su papel en la investigación aplicada sobre biomasa y bioproductos. Colaboración internacional con Canadá y con Rumania.Investigadores de… Lee más: Grupo VB&B se consolida en la Universidad del Bío-Bío